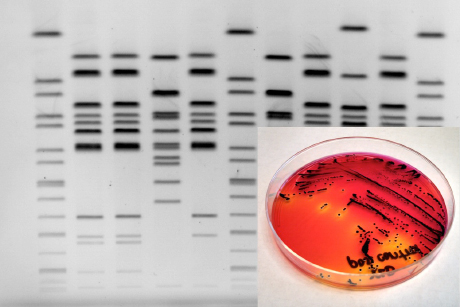
petri dish

Foodborne pathogen detection speeds up dramatically
By Stacey Shackford
New York is on the front lines of detecting foodborne pathogen outbreaks, thanks to a partnership between public health scientists and Cornell researchers.
Members of the Cornell Food Safety Lab, led by food science professor Martin Wiedmann and research associate Henk den Bakker, are helping the New York State Department of Health (NYSDOH) harness the capabilities and cost efficiencies of next-generation DNA sequencing techniques to rapidly identify strains of salmonella and read the results in a way that could quicken responses to potential outbreaks.
Traditional methods of assessing bacteria samples submitted to public health laboratories, based on pulsed-field gel electrophoresis (PFGE), often do not deliver the level of precision needed to pinpoint specific strains of pathogens, their relationships to each other and whether they share a common origin – vital information when trying to trace the source of illness outbreaks.
For Salmonella enterica serovar Enteritidis, for instance, 85 percent of isolates can be classified into just five PFGE types, and 40 percent belong to one subtype in particular.
“There’s so little variation in the genome, and when there’s an outbreak, it’s almost impossible to differentiate using that method,” den Bakker said.
By sequencing all 4.5 million base pairs of the bacteria’s DNA using single nucleotide polymorphisms (SNPS) in a technique known as rapid whole-genome sequencing, scientists are able to get much more nuanced information.
“This kind of detailed information improves our ability to tell whether outbreaks are isolated, sporadic or part of a cluster, which allows for more thorough epidemiologic investigations,” said NYSDOH collaborator William J. Wolfgang.
The introduction of small, affordable, bench-top, whole-genome sequencing equipment has made it possible for clinical and public health labs to consider adding the technology to their arsenal. The NYSDOH’s Wadsworth Center in Albany, New York, was one of the first public health labs to make the investment – Cornell was able to provide the bioinformatics expertise to enable the lab to make sense of the data it would be collecting and to analyze it quickly.
Their proof of concept was published July 16 in the Centers of Disease Control journal Emerging Infectious Diseases in a paper that uses a case study of a salmonella outbreak in a long-term care facility to demonstrate how the technique could benefit public health labs.
In a regional collaboration, samples collected by the Connecticut Department of Public Health were sequenced by NYSDOH and analyzed by Cornell, and researchers discovered the outbreak was even larger than suspected. In addition to the seven residents identified in 2010 as being sickened in the outbreak, nine additional samples from patients in surrounding communities matched the main strain.
“This suggests a common contaminated source outside the long-term care facility. Knowledge of these cases at the time of the outbreak might have improved the chances of finding the outbreak source, which was never identified,” the researchers wrote in the paper.
The technique is already gaining traction in several other states through the GenomeTrakr initiative sponsored by the U.S. Food and Drug Administration (FDA), which is providing sequencing equipment, reagents, funds for personnel, and training on the equipment to seven State Public Health Laboratories including New York. In return, the public health labs upload raw sequence data to a centralized site for analysis. Any clusters that appear are reported back to local labs and epidemiologists, allowing for a quick, coordinated response.
The study was partly funded by a grant from the USDA Agriculture and Food Research Initiative, the Center for Food Safety and Applied Nutrition at the FDA and the NYSDOH Wadsworth Center).
Stacey Shackford is a staff writer at the College of Agriculture and Life Sciences.
Media Contact
Get Cornell news delivered right to your inbox.
Subscribe